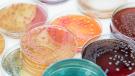

Není železo jako železo: Srovnání doplňků stravy
Solgar Železo (bisglycinát) 20 mg
Tento doplněk obsahuje 20 mg železa ve formě bisglycinátu, což je chelátová forma železa považovaná za velmi dobře vstřebatelnou. Hlavní výhodou bisglycinátu je jeho vysoká biologická dostupnost a šetrnost k zažívání, protože nezpůsobuje zácpu či podráždění žaludku, jako je tomu u jiných forem železa (např. síran železnatý).
Další složky:
- Plnidlo: mikrokrystalická celulóza
- Obal kapsle: hydroxypropylmetylcelulóza (vegetariánské kapsle)
- Protispékavá látka: stearát hořečnatý (E470b) z rostlinných zdrojů
Výhody: ✔ Dobrá vstřebatelnost ✔ Šetrnost k trávicímu traktu ✔ Čisté složení bez zbytečných aditiv
Nevýhody: ✖ Obsahuje pouze železo bez dalších synergických složek
G&G Vitamins Železo 50 mg
Tento produkt obsahuje 50 mg železa (bisglycinát). Bisglycinát je zde doplněn o další přírodní složky, které zvyšují jeho účinnost a vstřebatelnost:
Složení jedné kapsle:
- Železo (bisglycinát) (50 mg) – vysoká vstřebatelnost
- Vojtěška (110 mg) – přírodní zdroj živin
- Obal tobolky: rostlinná celulóza (100 mg)
Výhody: ✔ Vysoká dávka železa ✔ Dobře vstřebatelná forma bisglycinátu ✔ Přírodní čisté složení
Nevýhody: ✖ Vyšší dávka může být pro citlivé jedince příliš silná
Mattisson Tekuté železo
Tento doplněk obsahuje 13,16 mg železa ve formě fumarátu železnatého. Fumarát je sice dobře vstřebatelný, ale méně šetrný k žaludku než bisglycinát. Výhodou tohoto produktu je však tekutá forma, která umožňuje lepší vstřebatelnost u lidí s trávícími problémy.
Složení:
- Borůvkový koncentrát a medová směs – přírodní sladidla
- Vitamíny B1, B2, B6, B9 a B12 – důležité pro krvetvorbu
- Kyselina askorbová (vitamín C) – podporuje absorpci železa
- Kyselina citronová a malinové aroma – pro lepší chuť
Výhody: ✔ Tekutá forma vhodná pro osoby s trávicími problémy ✔ Obsahuje vitamíny podporující tvorbu červených krvinek ✔ Jemná, ovocná chuť
Nevýhody: ✖ Nižší dávka železa než u kapslí ✖ Obsahuje konzervační látky (sorban draselný)
Sana FE Železo
Tento produkt obsahuje 14 mg železa ve formě bisglycinátu s přídavkem dalších látek podporujících jeho vstřebávání.
Složení jedné kapsle:
- BIO Spirulina (200 mg) – zdroj živin a antioxidantů
- BIO akáciová guma (154,25 mg) – přírodní prebiotikum
- Bisglycinát železa (70 mg, z toho 14 mg elementárního železa, 100 % RHP) – vysoce vstřebatelná forma železa
- Camu-camu extrakt (17,68 mg) – obsahuje přirozený vitamín C, který podporuje absorpci železa
- L-methyl-tetra-hydrofolát vápenatý (B9) (5,5 mg) – důležitý pro krvetvorbu
- Laktoferin (2,5 mg) – zlepšuje vstřebávání železa
- Methylkobalamin (B12) (0,075 mg) – podporuje tvorbu červených krvinek
Výhody: ✔ Obsahuje vysoce vstřebatelný bisglycinát železa ✔ Přídavek vitamínů a přírodních složek pro podporu vstřebávání ✔ Vhodné pro osoby s vyšší potřebou železa
Srovnání a závěr
| Produkt | Forma železa | Obsah železa | Další složky podporující vstřebávání | Vhodné pro |
|---|---|---|---|---|
| Solgar Železo | Bisglycinát | 20 mg | Žádné | Běžné doplnění železa |
| G&G Vitamins Železo | Bisglycinát | 50 mg | Vojtěška | Lidé s vyšší potřebou železa |
| Mattisson Tekuté železo | Fumarát | 13,16 mg | Vitamíny B, C, borůvky, med | Lidé s trávícími problémy, děti |
| Sana FE Železo | Bisglycinát | 14 mg | Spirulina, Camu-camu, B9, B12, Laktoferin | Lidé, kteří chtějí dobře vstřebatelné železo se synergickými látkami |
Každý z těchto produktů má své výhody a nevýhody. Pokud hledáte silnější formu železa s doprovodnými živinami, pak Sana FE bude nejlepší volba. Pro běžné doplnění železa s šetrností k trávení je ideální Solgar. Pokud však máte problémy s polykáním kapslí nebo citlivý žaludek, pak je Mattisson tekuté železo vhodnou alternativou.
Nezapomínejte také na kombinaci železa s vitamínem C, která podporuje jeho vstřebávání, a vyhýbejte se konzumaci železa společně s vápníkem, mléčnými výrobky nebo kávou, které mohou jeho absorpci snižovat.
MK

Komentáře